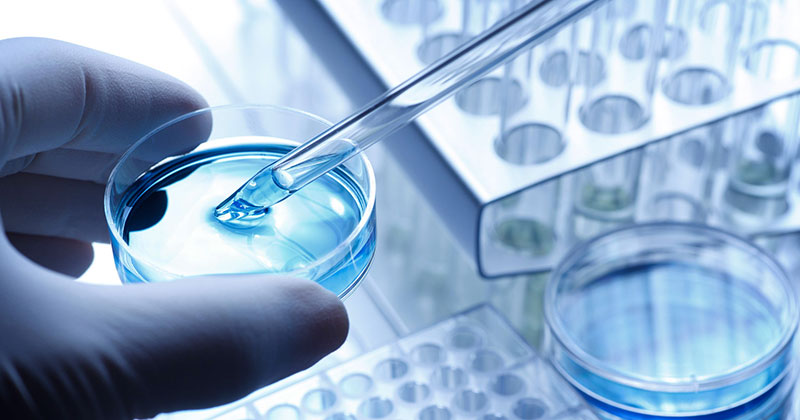

Nello specifico vi parliamo dello spray 74 e spray 77.
Adesivo Spray 74 ad elevatissima tenuta ed ottima resistenza allo strappo, rapida adesione, spruzzo a banda regolabile.
Incolla in modo permanente schiume, tessuti, imbottiti ed espansi per isolamento termico e isolamento acustico, adatto per fissare tappezzeria.
Adesivo Spray 77 multiuso trasparente dall’adesione rapida e tenace, asciugatura rapida, spruzzo a ventaglio regolabile in ampiezza.
Incolla in modo permanente carta, cartone, metallo e materie plastiche come polistirene ma spesso viene utilizzato anche per l’incollaggio di pellami, ecopelle, tessuti e tappezzerie auto dove è richiesto un assemblaggio rapido e pulito.
Contattaci per una consulenza gratuita 02 45076143.
#3m #adhesive #adesivispray #spray #assemblaggio #soluzioniadesive #biemmegroup #biemmeadesivi #tapesstore #isolamento #isolamentoacustico #isolamentotermico #incollaggiotessuti #incollaggioschiume